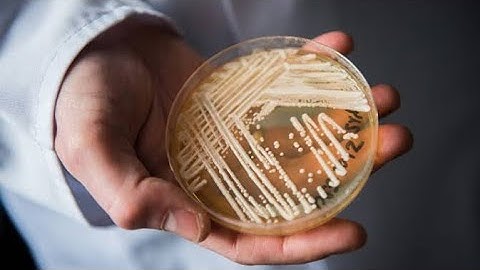
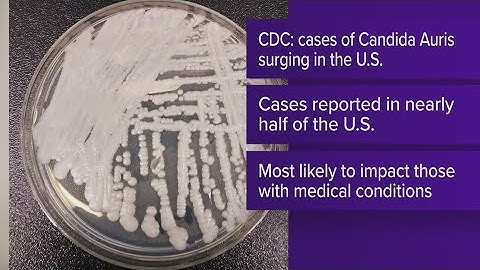

⬇ DOWNLOAD NOW
Kalau muncul iklan pop-up, tutup lalu klik tombol kembali
Download lagu CDC warns of deadly fungus secara gratis hanya untuk keperluan promosi. Dukung artis favorit kamu dengan membeli musik original di iTunes atau platform resmi lainnya.
 CDC warns dangerous fungus infection poses threat nationwide
CDC warns dangerous fungus infection poses threat nationwide
 CDC warns of deadly fungus spreading at alarming rate
CDC warns of deadly fungus spreading at alarming rate
CDC warns of drug-resistant fungal infection 2023
CDC warns of drug-resistant fungal infection 2023
 CDC warns of drug-resistant fungal infection
CDC warns of drug-resistant fungal infection
 CDC warns about a deadly fungus spreading in the US- Candida Auris
CDC warns about a deadly fungus spreading in the US- Candida Auris
CDC warns of 'alarming' recent rise of deadly fungus
CDC warns of 'alarming' recent rise of deadly fungus
 CDC warns potentially deadly fungus spreading at 'alarming rate'
CDC warns potentially deadly fungus spreading at 'alarming rate'
 CDC Warns Of 'Alarming' Rise Of Potentially Deadly Fungal Threat In Hospitals
CDC Warns Of 'Alarming' Rise Of Potentially Deadly Fungal Threat In Hospitals